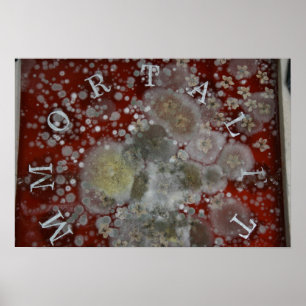
Immortality Poster

Popular Crab Posters
Popular Crab Posters
1,611 results
Vintage Illustration of the Tortoises Poster
Price£38.75
Hard at work. poster
Price£21.90
Zodiac Constellation Cancer Poster
Price£154.00
Stuffed Crab Print
Price£18.75
Maryland Home Heart State Poster Sign
Price£19.80
Vintage Illustration of the Tortoises Poster
Price£23.35
Vintage Frog Illustration Poster
Price£34.25
Vintage Crab Lobster Natural History Print
Price£17.35
Bridgetown Barbados Poster
Price£16.15
Blue Crab Print
Price£18.75
Print - Crab Apple Blossoms
Price£60.10
Cute Cancer Zodiac Poster
Price£49.65
Heading home after the hunt. poster
Price£24.60
The Successful Hunt. poster
Price£13.85
Sea Poster
Price£56.85
CRAB POTS PHOTO PRINT
Price£15.55
Crabapple Blossoms Poster
Price£42.15
Washing and weaponry. poster
Price£21.90
Steamed Crab Print
Price£18.75
Washing and weaponry poster
Price£21.90
Vintage Frog Illustration Poster
Price£38.75
Heading home after the hunt. poster
Price£24.60
Zodiac Series: Cancer Canvas/Poster Print
Price£29.55
Vintage Illustration of shellfish Poster
Price£15.70
Vintage illustration summer pattern poster
Price£124.00
Coastal- vintage blue crab print
Price£40.55
Journey to the Hunting Grounds. poster
Price£21.30
The Hunting Grounds. poster
Price£21.30
Seafood Eat It! Poster
Price£43.55
Vintage Cirripedia Ernst Haeckel Art Print
Price£16.15
Family Tradition Print
Price£18.75
Heading home after the hunt. poster
Price£24.60
The Hunting Grounds. poster
Price£19.80
Heading home after the hunt. poster
Price£24.60
Making weapons. poster
Price£13.85
Love Crab Photo Print
Price£12.00
The World at Night - Map, Space Poster
Price£35.95
Hermit Crab Holding Sign
Price£119.00
Vintage Lobster Traps Diagrams Poster
Price£22.90
Crab Apple Tree Blossoms Photo Print
Price£5.70
Monarch Butterfly I Poster
Price£31.90
Blue Crab Art Photo Print
Price£0.80
Crab apple blossom photo print
Price£86.05
Heading home after the hunt. poster
Price£10.70
Pike Place Market Poster
Price£18.45
Ghost Crab Photo Print
Price£5.70
Chesapeake Bay Bridge Poster
Price£51.55
Hermit Crab Print
Price£16.65
Chincoteague sunset poster
Price£36.30
Pink Crab Apple Flowers Photo Print
Price£64.15
The Zazzle Promise
Love It Guarantee
Don't love it? We'll take it back! 30-day returns “100% Love It Guarantee.”
Easy International Delivery
Hassle-free shipping with no surprise fees. We cover any customs & duties.
Secure Shopping Guaranteed
100% Secure payment with SSL Encryption.
Search Feedback
If you need help or have a question for Customer Service, please visit our Help Centre